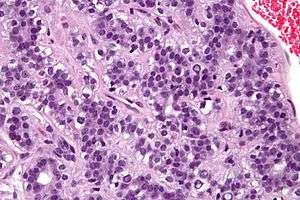

Adenomyoepithelioma of the breast
| Adenomyoepithelioma of the breast | |
|---|---|
|
Micrograph of an adenomyoepithelioma. H&E stain. | |
| Classification and external resources |
An adenomyoepithelioma of the breast, also adenomyoepithelioma, is a rare tumour in the breast composed of glandular elements (adeno-) and myoepithelial cells. It is usually benign;[1] however, there are reports of malignant behaviour.[2]
The histomorphologic appearance can mimic invasive ductal carcinoma, the most common type of invasive breast cancer.
See also
Additional images
-

Low mag.
-

High mag.
References
- ↑ Howlett, DC.; Mason, CH.; Biswas, S.; Sangle, PD.; Rubin, G.; Allan, SM. (Mar 2003). "Adenomyoepithelioma of the breast: spectrum of disease with associated imaging and pathology.". AJR Am J Roentgenol. 180 (3): 799–803. doi:10.2214/ajr.180.3.1800799. PMID 12591699.
- ↑ Zizi-Sermpetzoglou, A.; Vasilakaki, T.; Grammatoglou, X.; Petrakopoulou, N.; Nikolaidou, ME.; Glava, C. (2009). "Malignant adenomyoepithelioma of the breast--case report.". Eur J Gynaecol Oncol. 30 (2): 234–6. PMID 19480267.
External links
This article is issued from Wikipedia - version of the 2/3/2016. The text is available under the Creative Commons Attribution/Share Alike but additional terms may apply for the media files.